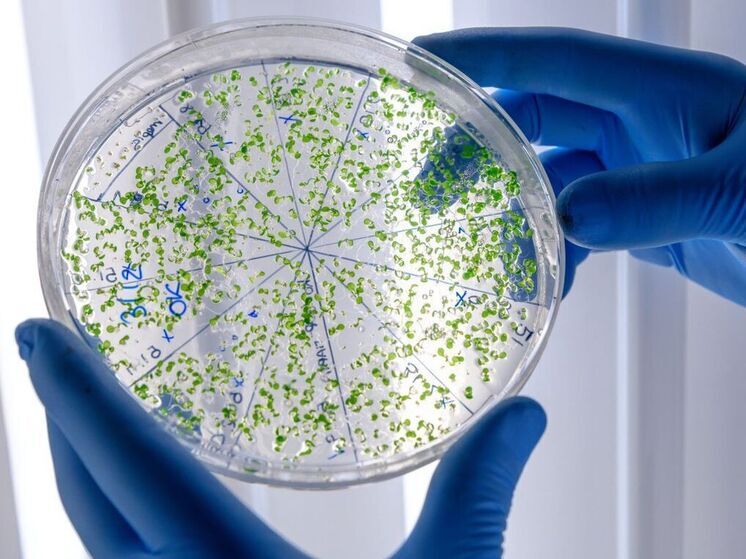
Ученые выяснили причину роста младенческой смертности

Проблема устойчивости патогенов к текущим антибиотикам достигает нового уровня. В предстоящие годы это может значительно отразиться на показателях младенческой смертности. Исследователи Сиднейского университета зафиксировали тревожный рост числа новорожденных с инфекциями, устойчивыми к антибактериальным средствам. Данные этого шокирующего исследования были опубликованы в журнале The Lancet Regional Health—Western Pacific.
Авторы исследования проанализировали почти 15 000 образцов крови, собранных у больных младенцев в 2019 и 2020 годах в десяти больницах пяти стран Юго-Восточной Азии, включая Индонезию и Филиппины. Они обнаружили стремительное распространение супербактерий, устойчивых ко многим известным антибиотикам, среди новорожденных.
«Наше исследование выявляет причины серьезных инфекций у младенцев в странах Юго-Восточной Азии с высокими показателями неонатального сепсиса и показывает тревожную распространенность устойчивости к противомикробным препаратам, которая делает многие из существующих методов лечения неэффективными для новорожденных», — подчеркнули авторы исследования.
При этом 80% инфекций новорожденных были вызваны такими бактериями, как кишечная палочка, клебсиелла и ацинетобактерия, которые имеют более высокую вероятность развития (и распространения) устойчивости к антибиотикам. Ранее считалось, что эти микроорганизмы вызывают инфекции только у детей старшего возраста, но теперь они заражают младенцев уже на первых днях жизни.
«Лечение, которое еще недавно считалось надежным, теперь при заражении супербактериями просто неэффективно. Кроме того, мы имеем дело с младенцами, у которых иммунная система недоразвита, и вес всего организма составляет всего 3-4 килограмма. Это значит, что инфекция прогрессирует быстро, и у врачей нет времени на перебор антибиотиков в поисках нужного», — говорит известный биолог Ирина Якутенко.
Причина текущей ситуации, в первую очередь, заключается в недостаточном учете местных особенностей бактериальной флоры при выборе препаратов. До сих пор в таких случаях медики назначали лекарства, основываясь на предыдущем опыте и результатах исследований. Однако со временем это становится все менее актуальным. При лечении младенцев у врачей нет времени ожидать результаты лабораторных анализов, чтобы точно определить причину инфекции, и они часто назначают терапию наугад. Кроме того, результаты анализов, если они вообще проводятся, часто задерживаются или оказываются ложноотрицательными из-за трудностей со сбором образцов крови.
Еще одной важной причиной является отсутствие новых антимикробных препаратов, находящихся на стадии разработки, для младенцев и детей младшего возраста. На одобрение нового антибиотика для применения у младенцев уходит около 10 лет. Учитывая, что новых кандидатов на лекарственные препараты и так очень мало, необходимы значительные инвестиции в разработку антибиотиков.
«Ситуация с антибиотикорезистентностью во всем мире ухудшается, а исследования на младенцах, если и проводятся, то в основном в богатых странах. При этом основная нагрузка от антибиотикорезистентности ложится на бедные страны. Но и в богатых странах у врачей часто нет второго шанса: разработка и одобрение антибиотиков для применения у младенцев обычно занимает много лет, а кандидатов очень мало. В настоящее время по всему миру проводится лишь несколько клинических испытаний новых антибиотиков для новорожденных, а также несколько проектов, проверяющих комбинации уже известных молекул», — рассказывает Якутенко.
Ученые подчеркивают, что сегодня все страны рискуют свести на нет десятилетия прогресса в снижении уровня детской смертности. Если ситуация не изменится, по словам Ирины Якутенко, новорожденные начнут умирать в значительно больших количествах, чем еще несколько лет назад.
…Антибиотикорезистентность ежегодно уносит 5 миллионов жизней, и пока не существует надежных способов справиться с этой проблемой.